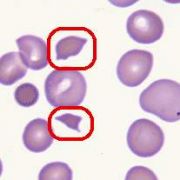

文件列表
来自医学百科
本特殊页面展示所有上传的文件。
| 日期 | 名称 | 缩略图 | 尺寸 | 用户 | 说明 | 版本 |
|---|---|---|---|---|---|---|
| 2014年1月17日 (五) 19:47 | Gq0or0g4.jpg (文件) |  |
16 KB | Admin | 1 | |
| 2014年1月17日 (五) 19:47 | Bkp32.jpg (文件) |  |
45 KB | Admin | 1 | |
| 2014年1月17日 (五) 19:47 | Bk7ni.jpg (文件) |  |
108 KB | Admin | 1 | |
| 2014年1月17日 (五) 19:47 | Guz0wxe7.jpg (文件) |  |
12 KB | Admin | 1 | |
| 2014年1月17日 (五) 19:46 | Bki29.jpg (文件) |  |
48 KB | Admin | 1 | |
| 2014年1月17日 (五) 19:46 | Bkpo5.jpg (文件) |  |
3 KB | Admin | 1 | |
| 2014年1月17日 (五) 19:46 | Gxqejhwb.jpg (文件) |  |
9 KB | Admin | 1 | |
| 2014年1月17日 (五) 19:46 | Bk1g0.jpg (文件) |  |
20 KB | Admin | 1 | |
| 2014年1月17日 (五) 19:46 | Bk2vl.jpg (文件) |  |
6 KB | Admin | 1 | |
| 2014年1月17日 (五) 19:46 | Bki5y.jpg (文件) | 16 KB | Admin | 1 | ||
| 2014年1月17日 (五) 19:46 | Bk0r5.jpg (文件) |  |
18 KB | Admin | 1 | |
| 2014年1月17日 (五) 19:46 | Bkkho.jpg (文件) |  |
8 KB | Admin | 1 | |
| 2014年1月17日 (五) 19:46 | Bkmtt.jpg (文件) |  |
19 KB | Admin | 1 | |
| 2014年1月17日 (五) 19:46 | Bk4no.jpg (文件) |  |
92 KB | Admin | 1 | |
| 2014年1月17日 (五) 19:45 | X bei.jpg (文件) |  |
90 KB | Admin | 1 | |
| 2014年1月17日 (五) 19:45 | Bkb6z.jpg (文件) |  |
12 KB | Admin | 1 | |
| 2014年1月17日 (五) 19:45 | Bkaqu.jpg (文件) |  |
33 KB | Admin | 1 | |
| 2014年1月17日 (五) 19:45 | Bkqgz.jpg (文件) |  |
65 KB | Admin | 1 | |
| 2014年1月17日 (五) 19:45 | Bklmy.jpg (文件) |  |
163 KB | Admin | 1 | |
| 2014年1月17日 (五) 19:45 | Gktm2omb.gif (文件) | 3 KB | Admin | 1 | ||
| 2014年1月17日 (五) 19:45 | Bkn6i.jpg (文件) |  |
288 KB | Admin | 1 | |
| 2014年1月17日 (五) 19:45 | Bkmom.jpg (文件) |  |
365 KB | Admin | 1 | |
| 2014年1月17日 (五) 19:45 | Bkc89.jpg (文件) |  |
24 KB | Admin | 1 | |
| 2014年1月17日 (五) 19:44 | Bkf6a.jpg (文件) |  |
2 KB | Admin | 1 | |
| 2014年1月17日 (五) 19:44 | Bk8ov.jpg (文件) |  |
84 KB | Admin | 1 | |
| 2014年1月17日 (五) 19:44 | Bk6cz.jpg (文件) |  |
8 KB | Admin | 1 | |
| 2014年1月17日 (五) 19:44 | Bkp2n.jpg (文件) |  |
15 KB | Admin | 1 | |
| 2014年1月17日 (五) 19:44 | Gktm6cdp.gif (文件) | 3 KB | Admin | 1 | ||
| 2014年1月17日 (五) 19:44 | Bkh3x.jpg (文件) |  |
80 KB | Admin | 1 | |
| 2014年1月17日 (五) 19:44 | Gl917ghj.jpg (文件) |  |
28 KB | Admin | 1 | |
| 2014年1月17日 (五) 19:44 | Bkqdk.jpg (文件) |  |
30 KB | Admin | 1 | |
| 2014年1月17日 (五) 19:43 | Bka7n.jpg (文件) | |
6 KB | Admin | 1 | |
| 2014年1月17日 (五) 19:43 | Glxeq9i8.gif (文件) |  |
37 KB | Admin | 1 | |
| 2014年1月17日 (五) 19:43 | Bkj80.jpg (文件) |  |
27 KB | Admin | 1 | |
| 2014年1月17日 (五) 19:43 | Bk0hh.jpg (文件) |  |
24 KB | Admin | 1 | |
| 2014年1月17日 (五) 19:43 | Gkpgz8jx.gif (文件) |  |
26 KB | Admin | 1 | |
| 2014年1月17日 (五) 19:43 | Gkruzui1.jpg (文件) |  |
6 KB | Admin | 1 | |
| 2014年1月17日 (五) 19:43 | Bkp7o.jpg (文件) |  |
99 KB | Admin | 1 | |
| 2014年1月17日 (五) 19:43 | Bkckv.jpg (文件) |  |
206 KB | Admin | 1 | |
| 2014年1月17日 (五) 19:42 | Bkgca.jpg (文件) |  |
106 KB | Admin | 1 | |
| 2014年1月17日 (五) 19:42 | Bk2q5.jpg (文件) |  |
66 KB | Admin | 1 | |
| 2014年1月17日 (五) 19:42 | Bkhlw.jpg (文件) |  |
174 KB | Admin | 1 | |
| 2014年1月17日 (五) 19:42 | Glwcdg09.jpg (文件) |  |
21 KB | Admin | 1 | |
| 2014年1月17日 (五) 19:42 | Bk39a.jpg (文件) |  |
55 KB | Admin | 1 | |
| 2014年1月17日 (五) 19:42 | Bkdq2.jpg (文件) |  |
113 KB | Admin | 1 | |
| 2014年1月17日 (五) 19:42 | Gm8u00xt.gif (文件) |  |
7 KB | Admin | 1 | |
| 2014年1月17日 (五) 19:42 | Bkhip.jpg (文件) |  |
92 KB | Admin | 1 | |
| 2014年1月17日 (五) 19:41 | Gxpuz3k0.jpg (文件) |  |
42 KB | Admin | 1 | |
| 2014年1月17日 (五) 19:41 | Bk7y7.jpg (文件) |  |
103 KB | Admin | 1 | |
| 2014年1月17日 (五) 19:41 | Bkeba.jpg (文件) |  |
58 KB | Admin | 1 |